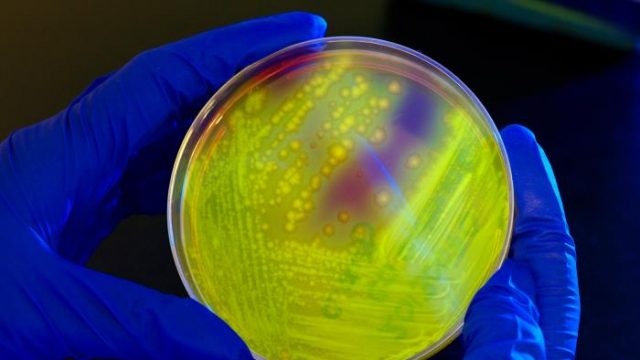

Laurel Legenza, Comparative Health System Global Pharmacy Fellow, and her mentors Warren Rose, associate professor (CHS), and Susanne Barnett, assistant professor (CHS) in the Pharmacy Practice Division at UW-Madison School of Pharmacy are part of a collaborative research project to address Clostridium difficile infection (CDI) in South Africa. The project brings together researchers at the University of Wisconsin-Madison School of Pharmacy and the University of the Western Cape in Cape Town in order to address the increasing CDI global problem. Partners in South Africa identified CDI as an area of crucial need. The aim of this quality improvement study is to determine the impact on outcome measures of implementing an inpatient CDI bundled checklist on patient outcomes.
The mixed-methods research approach will collect quantitative and qualitative data pre-post a quality improvement checklist intervention. The checklist will include items related to identifying, treating, and limiting the spread of CDI and will be used by interdisciplinary teams. Additionally, qualitative data collection will include interviews with key informants at the hospitals about current CDI practices and perceptions. Preliminary research is expected to begin in Cape Town in March 2016.
The project is one of the primary efforts of the novel Comparative Health System Global Pharmacy Fellowship at the UW-Madison School of Pharmacy and was developed in collaboration with Professor Angeni Bheekie and Dr. Renier Coetzee at the University of the Western Cape and Dr. Nasia Safdar, Clostridium difficile infection expert and associate professor. The quality improvement research project received ethical approval in South Africa in late February.